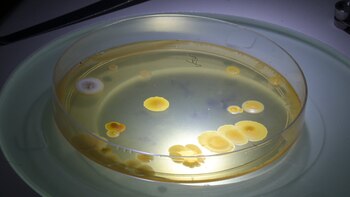
En palabras de Croci, director

En pleno barrio porteño de Parque Patricios, exactamente frente al hospital Garrahan, funciona un laboratorio que cumple un rol clave en la logística sanitaria de las Fuerzas Armadas: allí se elaboran insumos esenciales para proteger la salud de los miles de efectivos que están desplegados a lo largo y ancho del país para llevar adelante las misiones que les delega el Estado argentino.
El organismo funciona bajo la órbita del Estado Mayor Conjunto de las FF. AA., con un alto nivel de exigencia técnica y compromiso profesional. Para conocer los detalles del trabajo silencioso que realizan, DEF recorrió sus instalaciones y dialogó con el contraalmirante médico Alberto Hugo Croci, director de Sanidad Conjunto.
La sanidad en el escenario militar
En palabras del director de Sanidad Conjunta, el organismo que dirige tiene diferentes funciones. ¿La principal?, asistir y asesorar en la elaboración de políticas, planes y proyectos relacionados con la salud y el bienestar del personal militar.

“La Dirección celebra, este año, su 25 aniversario. Para eso, tenemos que tener un conocimiento de las capacidades en salud que tienen las tres Fuerzas, tanto de los hospitales militares móviles como de las instalaciones fijas. Además, tenemos la capacidad de gestionar el Laboratorio Farmacéutico Conjunto y los Centros de Salud Mental Conjuntos”, contó el oficial médico.
Al tiempo agregó que, desde hace un tiempo, se propusieron distintos objetivos, muchos de los cuales ya fueron concretados. En ese sentido, el contraalmirante agregó: “Esta dirección tiene a cargo, seis Centros de Salud Mental Conjuntos distribuidos en la Ciudad de Buenos Aires, Chaco, Curuzú Cuatiá (Corrientes), Córdoba, Puerto Belgrano (Buenos Aires), y Comodoro Rivadavia (Chubut). En ellos se brinda atención ambulatoria, integral y multidisciplinaria. Allí, un grupo de profesionales (de distintas ramas) está enfocado en el seguimiento y la contención del Veterano de Guerra de Malvinas y de sus herederos directos”.
Además, estos centros también se ocupan de la evaluación psicológica del personal seleccionado para cumplir Misiones de Paz en el exterior o para ser desplegado en la Antártida.

Las áreas de producción del laboratorio de las Fuerzas Armadas
Uno de los objetivos mencionados por Croci fue la reactivación del Laboratorio Farmacéutico: “Tiene una primera planta, “Caseros”, que antiguamente pertenecía al Ejército Argentino; la segunda se ubica dentro de la I Brigada Aérea, en El Palomar. Esas son nuestras dos áreas de producción”.
Cabe señalar que la reactivación del laboratorio coincide con la epidemia de dengue del año 2024. Por eso, en aquel entonces, el foco estuvo puesto en la elaboración del repelente como producto estratégico: “Somos militares y combatimos de diferentes formas. Además de las campañas de prevención, tenemos que contar con elementos para mitigar. El detalle es que este laboratorio contaba con una autorización, por parte de la ANMAT, para la elaboración en campaña. Entonces, nos propusimos producir repelente. Finalmente, en junio de 2024 fabricamos una primera tanda. Cabe destacar que este artículo es cosmético, no farmacéutico”.

“Todos se pusieron al hombro este compromiso”
En cuanto a la producción del repelente, en la planta de Caseros el personal se encargó de todas las etapas de la producción. Por ejemplo, se analizaron las características que debía tener el envase y la calidad de las materias primas, se capacitó a los profesionales que estarían abocados a la elaboración, y hasta se hicieron campañas para conocer en profundidad el virus del dengue y la importancia de trabajar en ese producto como medio de prevención.
“Todos se pusieron al hombro este compromiso y fue por eso que, en pocos meses, obtuvimos nuestra primera producción. Eso fue un disparador muy interesante, porque pudimos llegar a todas las unidades de las Fuerzas Armadas y abastecer a los hospitales y barrios militares. Poco tiempo después tuvo lugar la inundación en Bahía Blanca, así que también pudimos enviar parte de la producción al lugar del desastre (además de alcohol en gel)”, recordó el contraalmirante, y agregó que están trabajando para contar con la habilitación definitiva (pensando exclusivamente en la elaboración de productos cosméticos) de la planta de Caseros.
Un dato relevante: desde el Laboratorio tienen capacidad para elaborar 5.000 repelentes por semana. “Es un número importante considerando la cantidad de efectivos de las FF. AA.”, adelantaron.
Enjuagues bucales, desodorantes para los pies y algunos antisépticos están entre los objetivos a futuro del Laboratorio. “Estamos trabajando en el análisis de diferentes líneas de producción”, advirtió el oficial.

Análisis de agua para el consumo del personal militar
Otro de los logros más importantes del último tiempo fue la instalación de un laboratorio enfocado en el análisis del agua a través de la incorporación de equipamiento de última generación.
“Podemos hacer el análisis físico-químico del agua y, por otro lado, el bacteriológico. Entonces, el agua que se consume, podemos evaluarla aquí. Este logro respondió a una necesidad que tenían los elementos militares. Algo muy importante: todo esto se hace gracias al personal de médicos, farmacéuticos y bioquímicos -tanto civiles como militares- con los que contamos”, dijo el contraalmirante.
Cabe señalar que, otro de los resultados fundamentales, fue haber avanzado en la incorporación de soldados especializados para profundizar el trabajo del Laboratorio. En este aspecto, se sumaron egresados -técnicos químicos- de una escuela secundaria de El Palomar: “Todos ellos están estudiando una carrera universitaria, pero, además, ya tienen el título intermedio que les dio el colegio. Son ellos quienes trabajan con el equipamiento y bajo la conducción de nuestra directora Técnica, la vicecomodoro Silvia Paredes, y del director del Laboratorio, capitán de navío farmacéutico Claudio Brillaud-Mc Queen. La verdad es que pudimos conformar un gran equipo de trabajo, también con las subdirecciones Sanitaria, a cargo del capitán de navío médico Alejandro Taleb, y Operativa, cuyo responsable es el coronel Cristian Lauletta”.

Justamente, fue el capitán de navío Brillaud Mc Queen quien contó a DEF que el Laboratorio recibe las muestras de las distintas unidades militares: “En lo que respecta al análisis bacteriológico, se miden bacterias coliformes, la presencia de Escherichia coli, por ejemplo. También se realiza un análisis extra para evaluar la presencia de amoníaco, arsénico, plomo, hierro y flora”, contó el oficial farmacéutico, al tiempo que agregó que también se realiza un estudio físico-químico, con foco en aspectos como el pH, el cloro, y la alcalinidad, entre otras características a tener en cuenta.
Mientras describe a DEF el escenario de trabajo, a su lado, los jóvenes técnicos químicos (que en el presente estudian carreras como medicina y física) avanzan con los análisis. Obviamente, allí también se desempeña personal con varios años de experiencia en el laboratorio. Uno de ellos contó que, en el pasado, el lugar realizaba investigación y producción biológica, como sueros antiofídicos y vacunas.

“Es muy importante el control de calidad”
En palabras de Croci, uno de los objetivos más relevantes es avanzar en las obras de la planta de El Palomar, enfocada en la producción de medicamentos: “Donde se producen cosméticos no se pueden elaborar medicamentos. Por eso estamos mejorando la El Palomar”.
El dato: la ANMAT es el ente regulador y es el organismo que tutorea el cumplimiento de todas las normas que rigen la producción del Laboratorio de las FF. AA. En ese sentido, Croci fue contundente: “Es muy importante el control de calidad, tanto de la materia prima, como del producto intermedio y el final”.
Asimismo, el oficial contó que uno de los aspectos más importantes es que cuentan con un desarrollo científico y tecnológico relevante. Ello, y el recurso humano capacitado, son los valores agregados fundamentales de este organismo estratégico para el cumplimiento de las misiones que el personal militar cumple en cada despliegue.
De hecho, el contraalmirante advirtió que la Dirección también es la responsable de recibir y distribuir las vacunas (las que integran los planes de vacunación y aquellas específicas para las distintas misiones) que el Ministerio de Salud de la Nación envía.
Medicina militar y táctica para el combate
La Dirección también está enfocada en la formación de los efectivos: “Tenemos que capacitarnos en materia de medicina militar y táctica y en sanidad en combate. Este año hicimos el curso denominado “Tactical Combat Casuality Care”, dictado por el Comando Sur de los Estados Unidos. Se trata de una capacitación que tiene cuatro niveles, en abril se dictó el primero y, los 73 egresados que tuvimos se graduaron como instructores para continuar avanzando en las siguientes etapas”.
Obviamente, esa no es la única formación que brindan. Por ejemplo, además de cursos específicos en el manejo de equipamiento, en septiembre próximo, se realizarán las jornadas científicas de medicina militar y táctica (en conmemoración del 25º aniversario de la Dirección de Sanidad Conjunta). Momento en el que contarán con la palabra del personal de sanidad que participó de la Guerra de Malvinas y que fue parte de distintas Misiones de Paz.
En palabras de Croci, esta última instancia también es relevante porque, quienes están haciendo las residencias de salud en los hospitales militares, podrán presentar sus trabajos de investigación.
“Además, somos parte del Comité Internacional de Medicina Militar, donde están representados 120 países. En mi caso, soy el delegado argentino. Es importante porque se estudian y publican los avances en la materia”, resaltó.

¿Por qué ingresan profesionales de Sanidad a las Fuerzas Armadas?
Además del personal militar de carrera, las Fuerzas Armadas están integradas por profesionales de la salud. Son ellos los que atienden y cuidan a los soldados, tanto en tiempos de paz como de guerra. Nada nuevo, ya en La Ilíada, Homero habla de Machaón, un médico guerrero que, al caer herido, lo alejaron del combate para preservarlo, pues “un médico vale él solo más que muchos combatientes; él sabe sacar los dardos de las heridas y calmar con bálsamos suaves los sombríos dolores”.
Croci es uno de esos profesionales: “Es una combinación muy linda. No quiero ser autorreferencial. Sí recuerdo que, cuando de pequeño, me preguntaban que quería ser de grande, yo respondía “médico y marinero”. Cuando terminé mis estudios de medicina, ingresé a la Armada, Fuerza que me dio muchas posibilidades. Hoy desempeño una tarea específica que requiere de alguien capacitado en salud”.

En palabras del contraalmirante (especialista en medicina nuclear y, posteriormente, formado en gestión) en un presente en el que el ámbito de la salud es cada vez más interdisciplinario, es fundamental contar con personal capacitado. Por ello, recordó, las FF. AA. suman a sus estructuras médicas, farmacéuticos, enfermeros, bioquímicos e, incluso, veterinarios y psicólogos.
Últimas Noticias
Cómo las iniciativas de Estados Unidos están impactando en el avance de China en América Latina
En un escenario marcado por presiones, repliegues y oportunidades, las decisiones de Estados Unidos buscan reconfigurar el terreno sobre el que China proyecta su influencia en la región. ¿Cuál es el resultado de las políticas de la administración de Trump?

La hora de la inteligencia artificial: avances, aplicaciones y el desafío de un desarrollo ético en Argentina
Esta nueva tecnología atraviesa una etapa de expansión sin precedentes, transformando desde la economía global hasta la vida cotidiana. Argentina busca posicionarse en este nuevo paradigma tecnológico, en un contexto mundial donde la ética, la energía y la gobernanza digital se vuelven tan decisivas como los avances técnicos

La perestroika cubana: ¿reforma real o el último intento del régimen para quedarse en el poder?
A 40 años de la reforma política y económica implementada por Mijaíl Gorbachov en la Unión Soviética, Cuba parece imitar su modelo para salvaguardar el régimen

Guerra en Irán: cuál es la diferencia entre árabes y persas, y por qué esta distinción es clave en Medio Oriente
El escenario internacional actual, con Irán como protagonista, hace necesario el abordaje de un tema clave para comprender qué sucede en Medio Oriente: ¿cuál es la diferencia entre estas dos culturas milenarias?

Microsoft y Fundación Taeda debaten sobre IA en Montevideo: desempleo, regulación y oportunidades para la región
En el marco de la presentación del libro Inteligencia Artificial para el Bien, Juan Lavista desarrolló más sobre los conceptos que se abordan en sus páginas con Nicolás Jodal, cofundador y CEO de GeneXus by Globant, y Daiana Beitler, PhD en Sociología y exdirectora de Filantropía de Microsoft Asia


